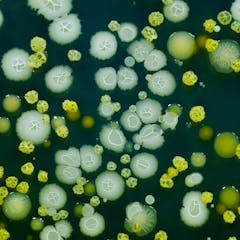

El CSIC es la primera institución pública de investigación en España y la tercera europea, tanto por la calidad como por la cantidad de su producción científica. Juega un papel esencial como actor imprescindible en el Sistema Español de Ciencia, Tecnología e Innovación, contribuyendo a fortalecer el posicionamiento de España en el ámbito científico internacional.
Su principal objetivo es desarrollar y promover investigaciones que contribuyan al progreso científico y tecnológico. Además, según establece el artículo 4 de su Estatuto de creación, su misión es fomentar, coordinar, desarrollar y promover la investigación científica y tecnológica, de carácter multidisciplinar, con el fin de contribuir al avance del conocimiento y el desarrollo económico, social y cultural, así como asesorar a entidades públicas y privadas sobre asuntos de su competencia.
El CSIC está presente en toda la geografía española gracias a sus 120 centros e institutos, así como en Bruselas y en Roma, donde ejerce su función un personal de muy variada titulación académica y de muy diferentes categorías administrativas. A ello se suma su participación en otras entidades jurídicas como fundaciones, consorcios o sociedades mercantiles.
El CSIC tiene 11.000 empleados, de los cuales más de 3.000 son investigadores. El CSIC tiene el 6% de todo el personal dedicado a I+D en España y genera aproximadamente el 20% de toda la producción científica del país.
The CSIC is the leading public research institution in Spain and the third in Europe, both for the quality and the quantity of its scientific production. It plays a fundamental role as essential actor in the Spanish system of science, technology and innovation, helping to strengthen Spain’s position in the international scientific field. Its main objective is to develop and promote research that will help bring about scientific and technological progress, and it is prepared to collaborate with Spanish and foreign entities in order to achieve this aim.
Furthermore, according to its Statute (article 4), its mission is to foster, coordinate, develop and promote scientific and technological research, of a multidisciplinary nature, in order to contribute to advancing knowledge and economic, social and cultural development, as well as to train staff and advise public and private entities on this matter.
The CSIC is present throughout the Spanish geography, with 120 centres and institutes, as well as in Brussels and in Rome. The CSIC staff has highly varied academic qualifications and belong to very different administrative categories. This is in addition to its participation in other legal entities such as foundations, consortia or companies.
Its more than 11,000 staff, of whom ore than 3,000 are staff researchers and the same number again are doctors and scientists who are still training. CSIC has 6% of all the staff dedicated to Research and Development in Spain, and they generate approximately 20% of all scientific production in the country.